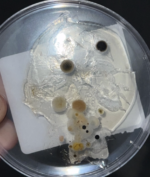
Dorm Maintenance Series: Past Issues With Mold

LATEST NEWSEXPLORE ALL
What the UCO Library Recommends to Plant in Your Garden
The University of Central Oklahoma’s Chambers Library hosted a seed exchange on April 23 as part of Earth Day to educate and give people the opportunity to grow their own plants. Nicole Sump-Crether, the director of library technology and data ... Read More